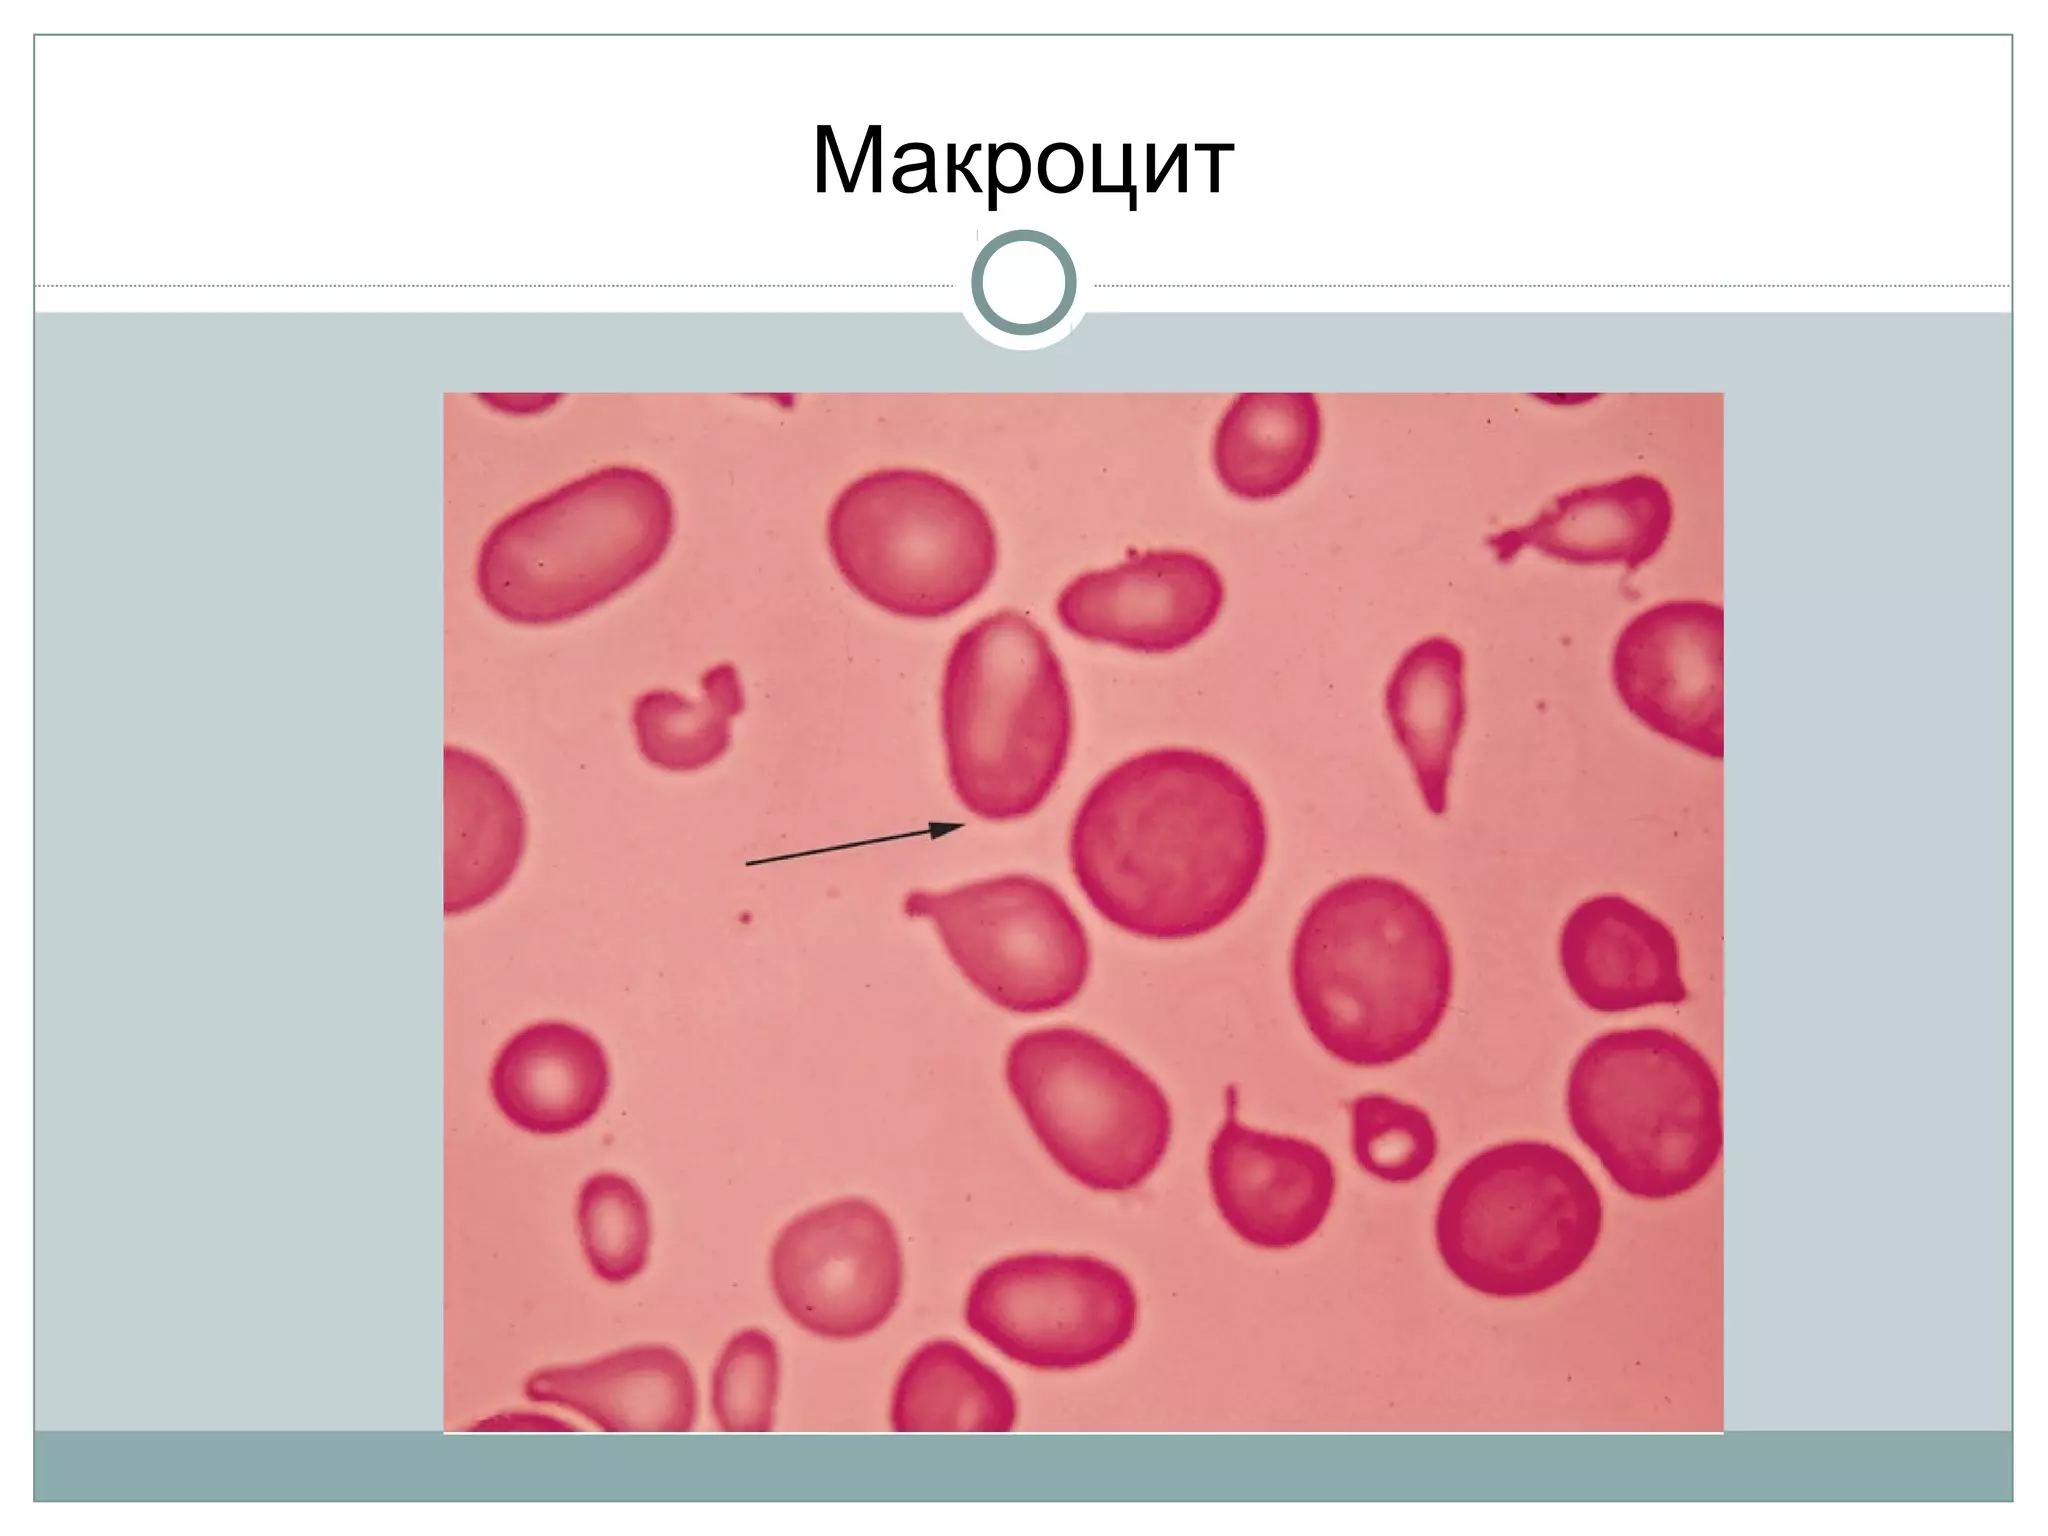
Макроцит
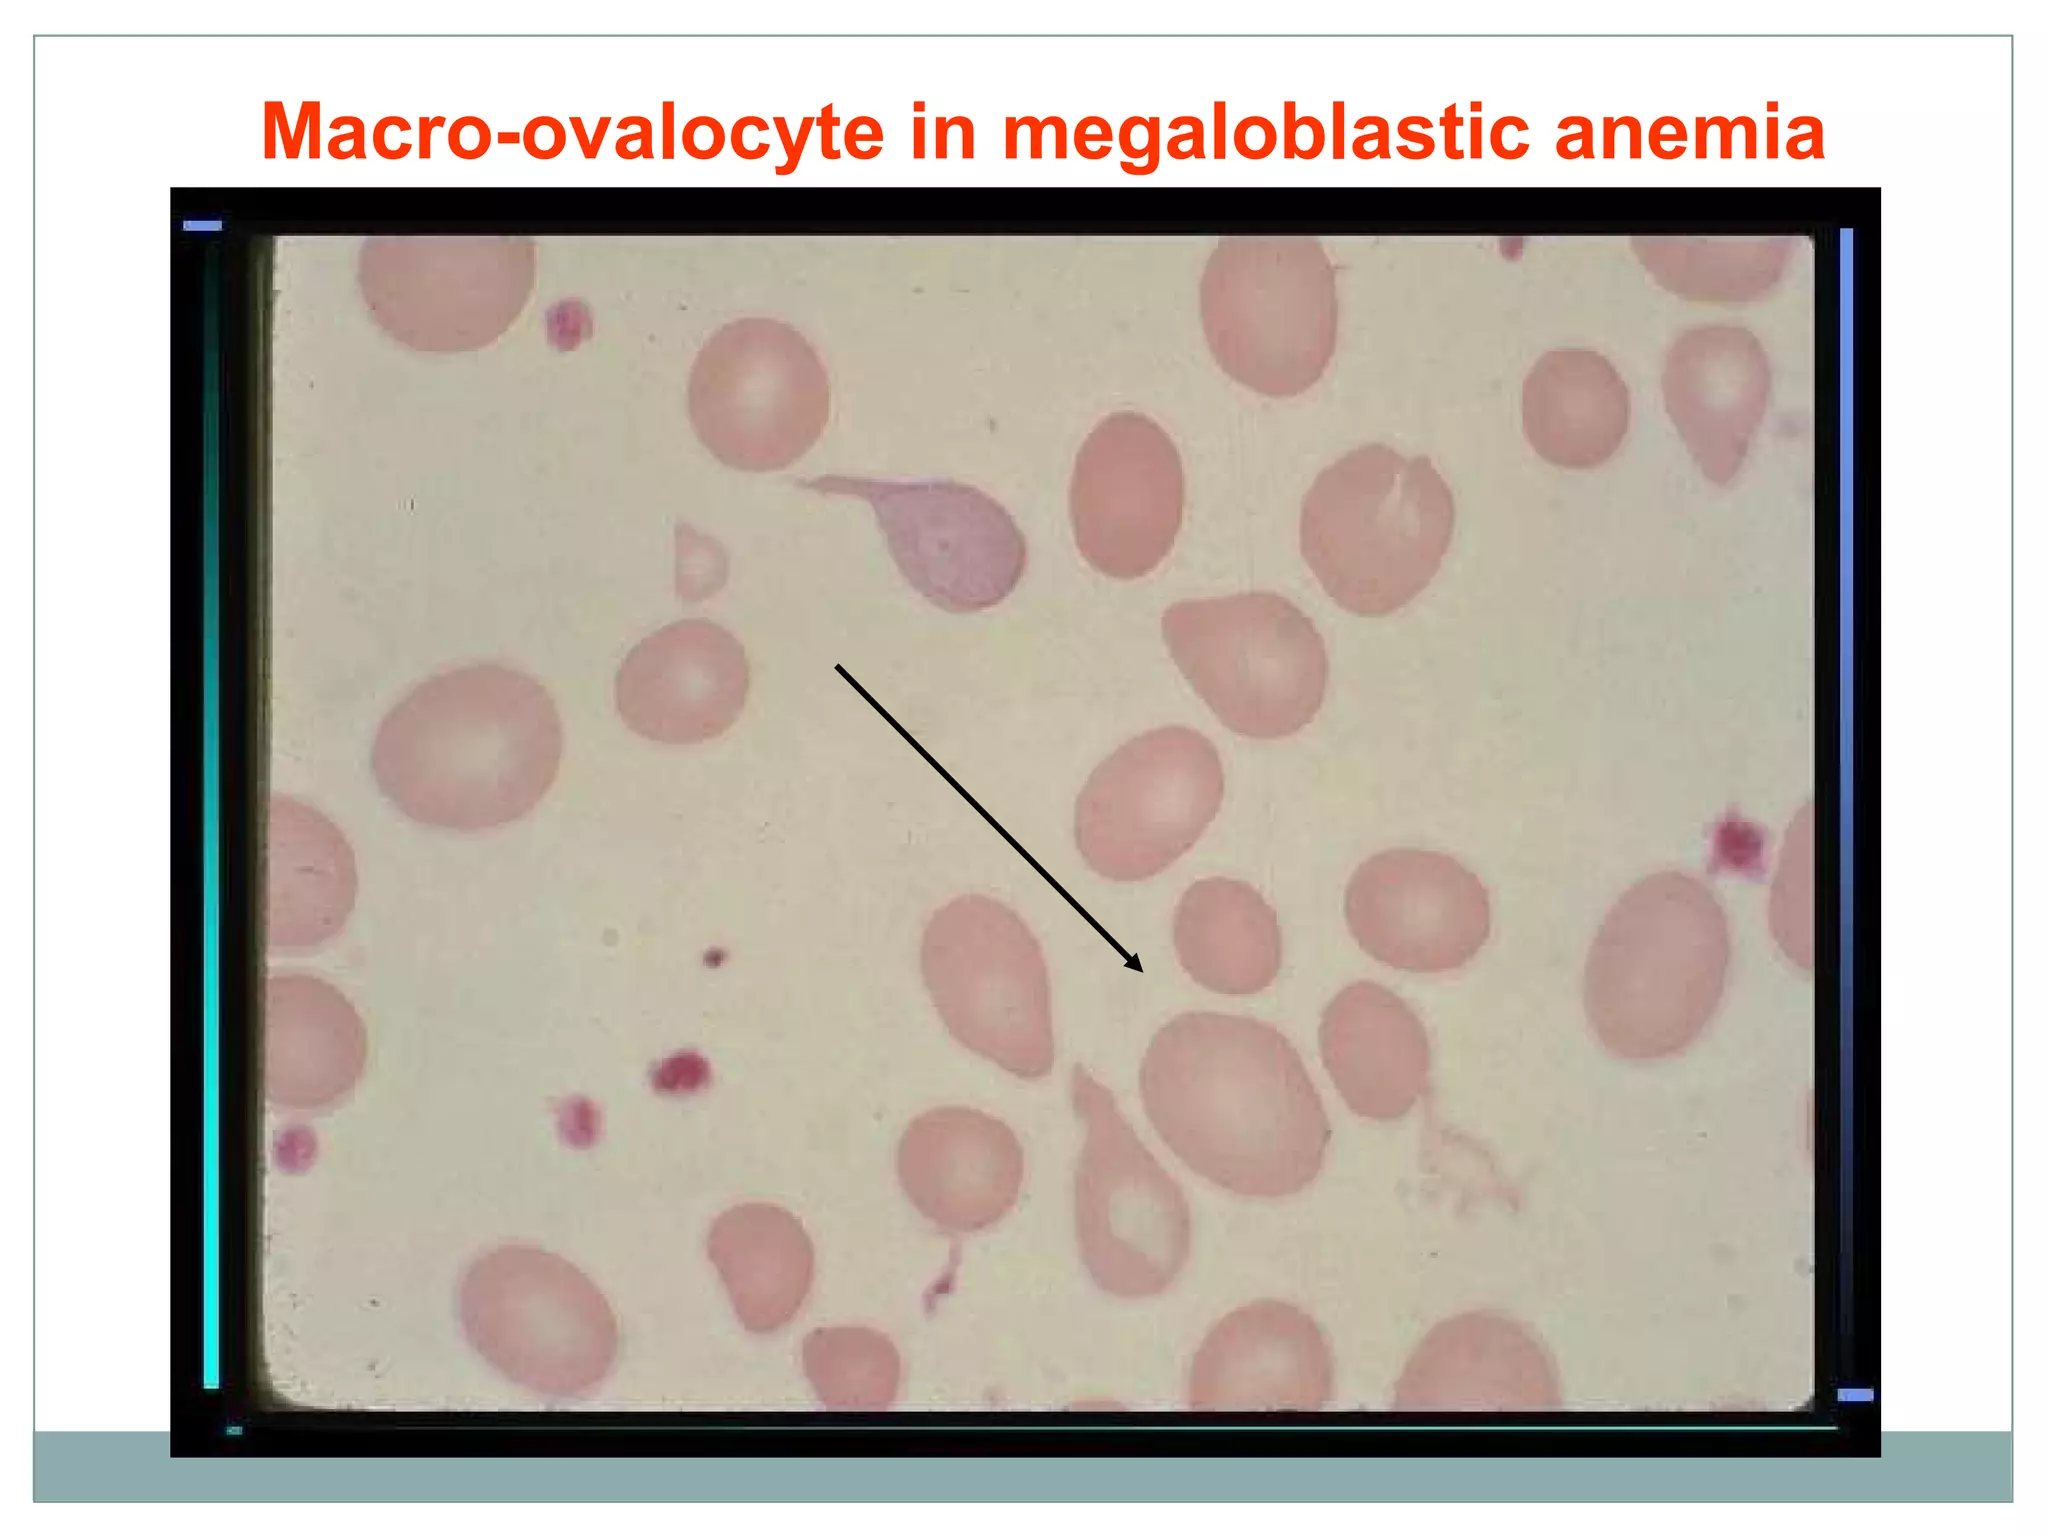
Macro-ovalocyte in megaloblastic anemia
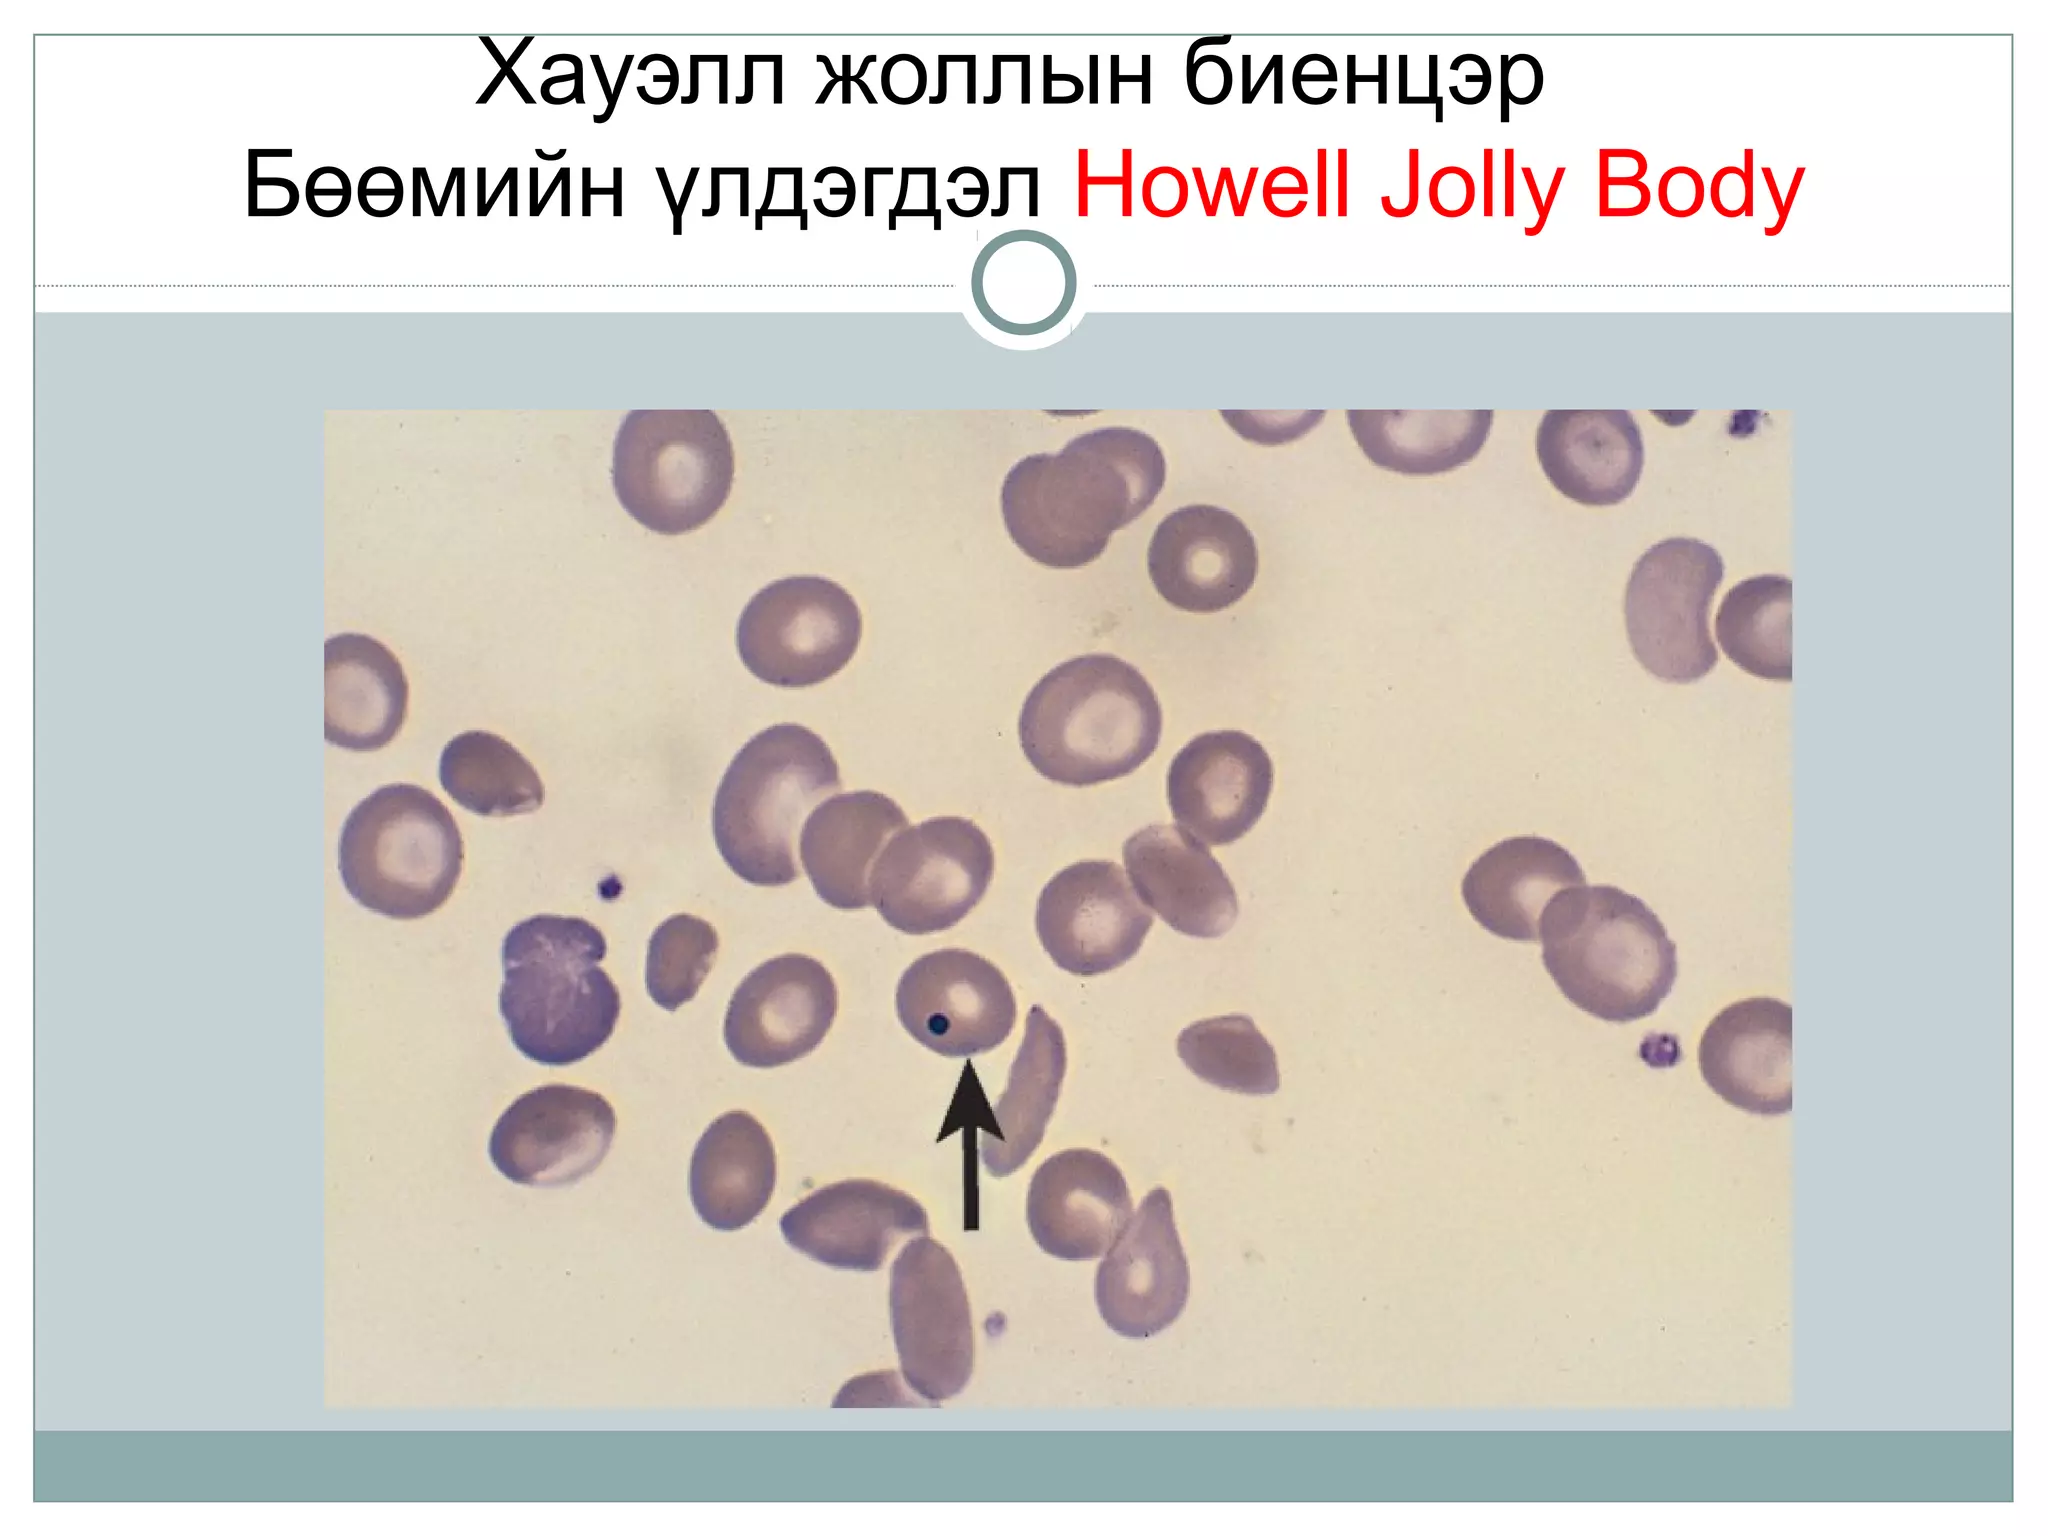
Хауэлл жоллын биенцэр
Бөөмийн үлдэгдэл Howell Jolly Body
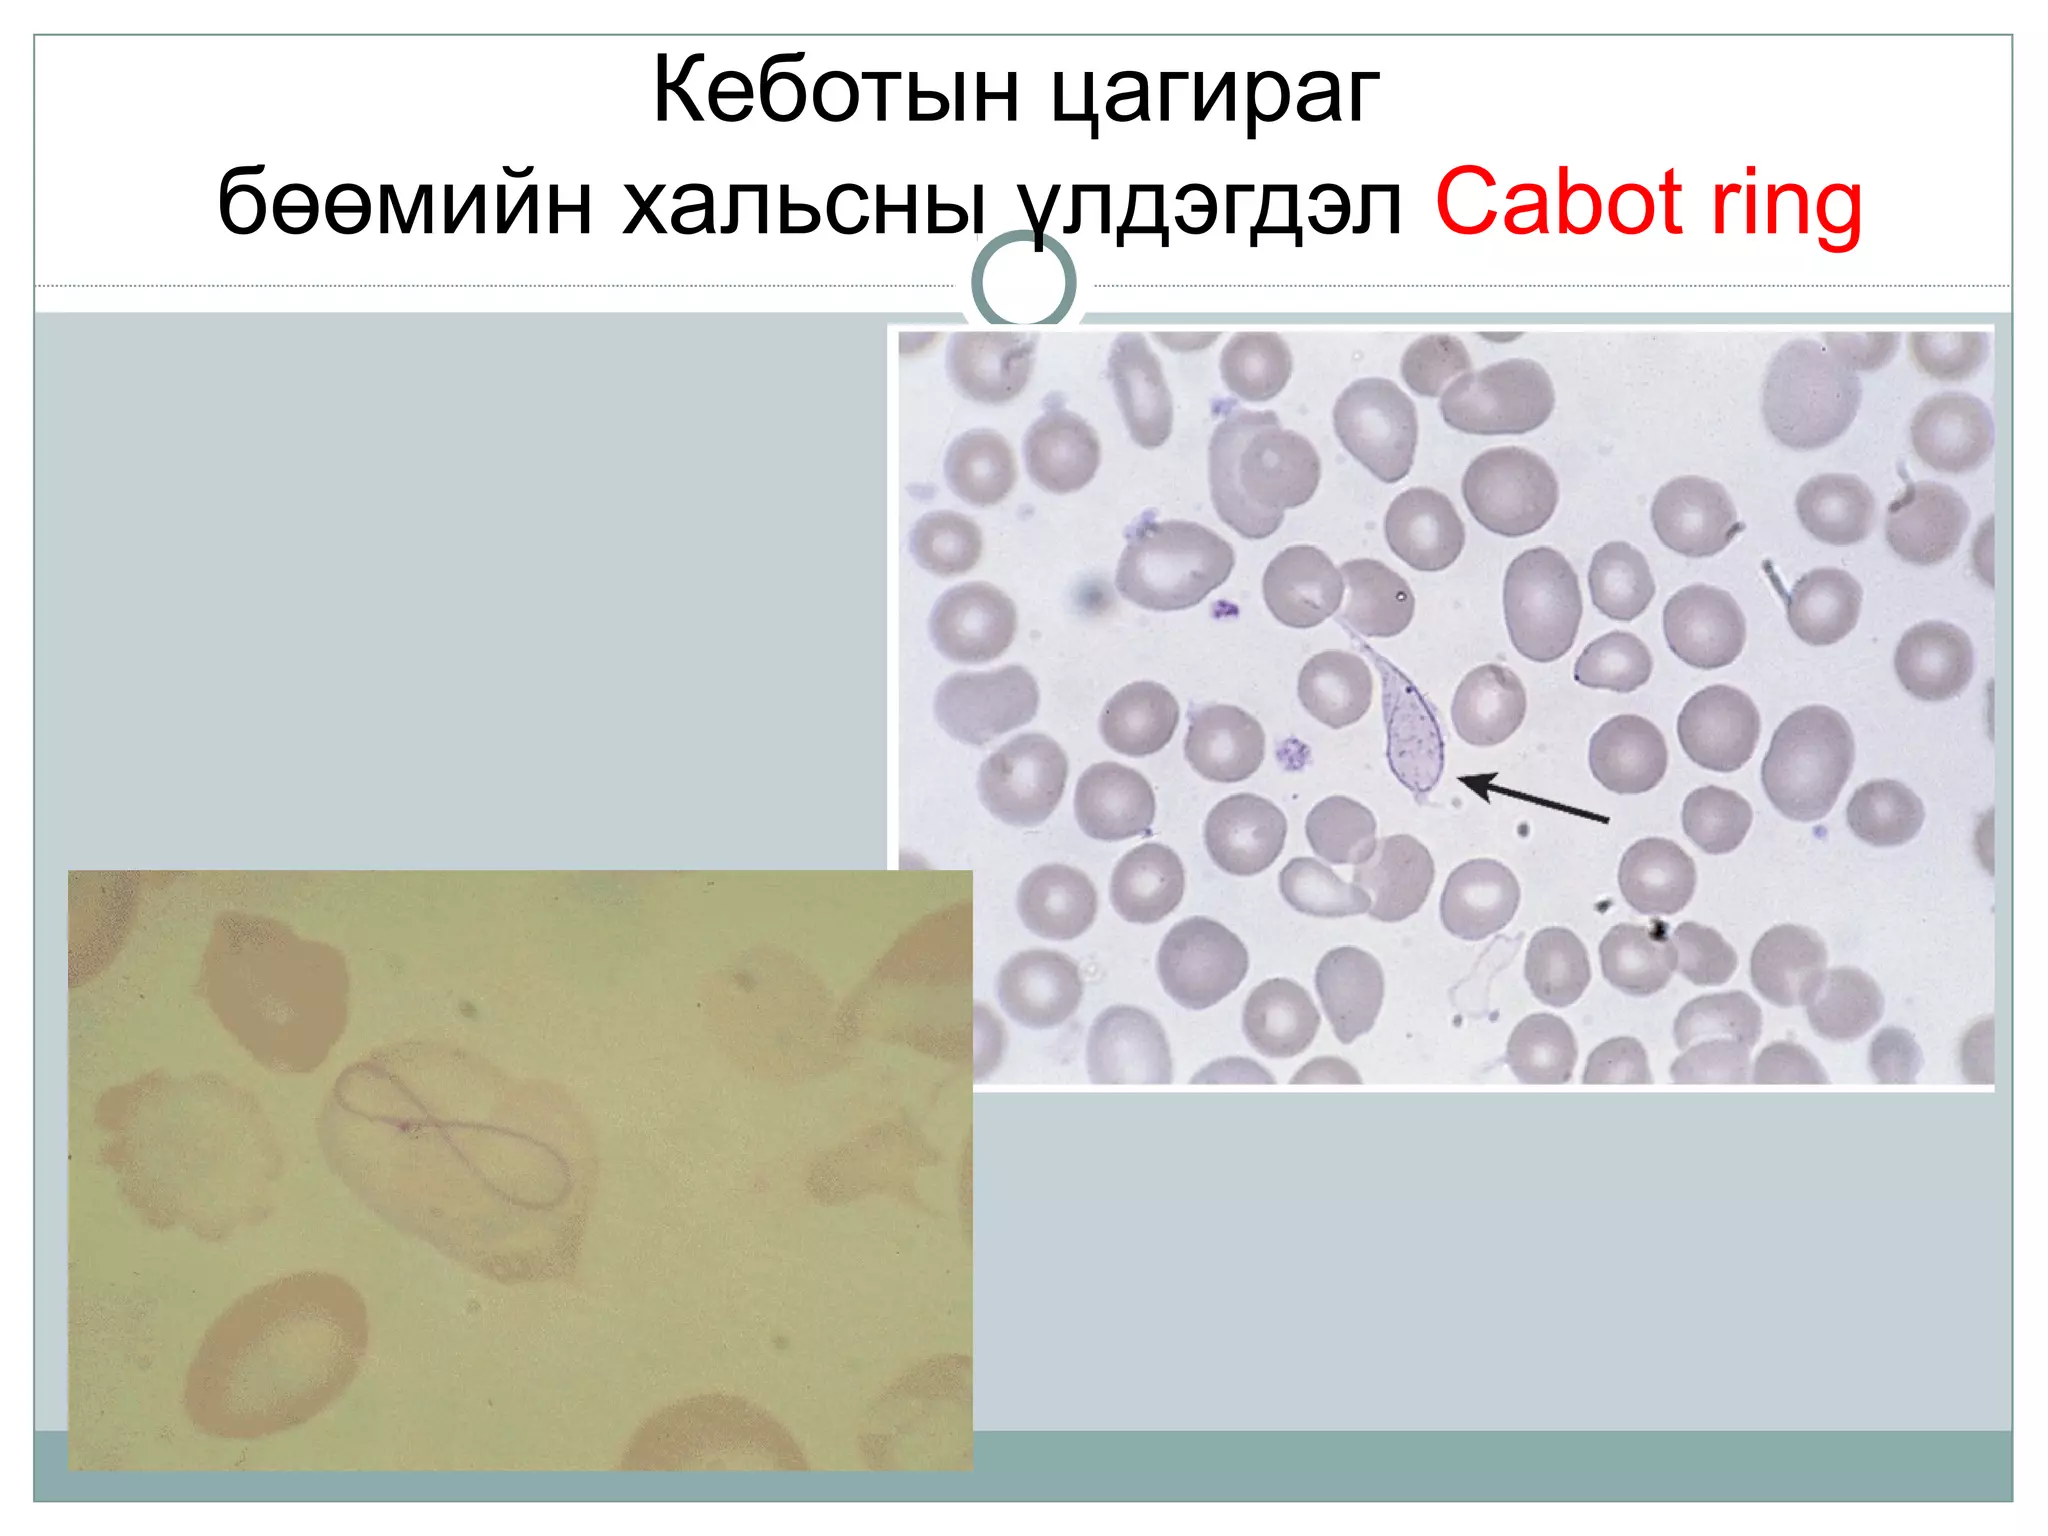
Кеботын цагираг
бөөмийн хальсны үлдэгдэл Cabot ring

More Related Content
PPTX
PPT
диатез, рахит, тураал, цу с багадалт 2013 д.м PPTX
PPTX
PPTX
PPTX
PPTX
PPTX
бөөр ялгаруулах тогтолцооны эмгэг What's hot
PPTX
PPTX
PPTX
Amisgal lecture 20146.11.13 PPT
PPTX
PPTX
PPTX
Zurh sudasnii ovchnii yalgan onoshlogoo DOC
бага насны хүүхдийг чийрэгжүүлэх тухай PPTX
PPTX
PPTX
PPTX
PPTX
PPTX
PPTX
PPTX
PPTX
PPTX
PDF
PPTX
Viewers also liked
PPTX
PPTX
дулааны шалтгаант Цус задралын цус багадалт PPTX
PPTX
PPTX
PPTX
жирэмсэн үеийн хэвийн үзүүлэлтүүд PPT
Ходоодны хавдар ( Gastric cancer ) PPT
Anemia And Its Classification PPT
PPTX
PPTX
та жирэмслэхээр төлөвлөж байгаа бол дараах зүйлсэд анхаарах PPTX
Hemolytic anemia Цус задралын цус багадалт Олдмол DOCX
PPT
лейкоцитоз, лейкопенія, лейкоз PPT
PPT
түнхний төрөлхийн мултрал PPTX
Жирэмсэн үеийн эрүүл ахуйн хяналт PDF
Гэрээр үзүүлэх сувилахуйн тусламжийн хэрэгцээг тодорхойлсон судалгаа PPTX
PPTX
жирэмсний хяналтын ач холбогдол Similar to B12 фолийн хүчлийн дутагдлын анеми ppt
PPTX
PPTX
DOCX
DOCX
DOCX
PPTX
элэгний циррозын цус алдалт DOCX
Өвчтний түүх, сүрьеэ кэйс PPTX
PPTX
Boornii dutagdal yaraltai tuslamj PPTX
Биохимийн хичээлд зориулж багаараё хийсэн сурах бичигт тулгуурласан бие даалт PPTX
Биохимийн хичээлд зориулж багаараё хийсэн сурах бичигт тулгуурласан бие даалт PDF
DOCX
ЭЛЭГНИЙ ДУТАГДАЛ- цочмог дутагдал 2023он DOCX
DOCX
PPTX
Copy of Stomach Bacterial Infection Disease by Slidesgo.pptx PPTX
шээсний ерөнхий шинжилгээ PPTX
PPTX
DOCX
More from Zoloo Ganbat
PPT
Түнхний төрөлхийн мултрал PPT
PPTX
Amidraliin tugsguliin shatand uvchtnii setgelzuin ontslog PPT
биений юмны үйл ажиллагааны алдагдал PPT
дархлааны механизмаас хавдрын эс зайлсхийх PPT
B12 фолийн хүчлийн дутагдлын анеми ppt
- 1.
- 2.
В12 витамин
Насанд хүрсэнэрүүл хүний биед 2-5 мг В12 агууллагддаг.
1000 мкг элгэнд нөөцлөгддөг
В12 сийвэн дэх агууламж – (200-900 пг/мл)
- 5.
- 6.
- 7.
- 8.
- 9.
- 10.
- 13.
Шалтгаан
Хоол тэжээлээр хангалттай
хэмжээнийВ12 авч чадахг йү
байх
Цагаан хоол, хоол тэжээлийн хомсдол
В12 шимэгдэлт алдагдах Хорон цус багадалт, ходоодны шарх, ходоод
гэдэс тайрагдах, нарийн гэдэсний йлү
ажиллагаа хямрах
Эм /бигуанид, колхицин, неомицин/
В12 хэрэгцээ ихсэх Жирэмсэн, х х л е, гипертиройдизм, хортө үү ү
хавдар, архаг цус задрал
В12 зарцуулалт ихсэх Шимэгчид, дисбактериоз, дивертикул, мухар
гэдэс тайрагдсаны улмаас залгагдах
В12 н ц багасахөө Элэгний тархмал хатуурал, элэгний архаг
идэвхитэй рэвсэлү
Дархлалын шалтгаан Эсрэг бие сэх, аутоиммуны эмгэгүү
Генетикийн х чин з йлү ү Т р лхийн дархлаа дутал, цусны А б лэгө ө ү
- 14.
- 15.
- 16.
- 18.
Цусны шинжилгээнд гарахөөрчлөлт
Улаан эс цагаан эс ялтас эс цөөрөх панцитопени
Гиперхромын цус багадалт MCH ӨИ>1.2
Макроцит мегалоцит MCV
Анизоцитоз пойкилоцитоз RDW
Ретикулоцит тоо
Арьс салст бага зэрэг шарлах
Элэг дэлүү томрох
/мегалоцит эсүүд ретикуль-эндотелийн гарахдаа гэмтэх/
- 19.
- 20.
- 21.
Захын цусны түрхэц
Жоллийн биет
Кеботын цагираг
Нейтрофиль гиперсегментаци
Мегалобластын тоо олширсон
Аварга том мегакариоцит, метамиелоцит
Хүнд үед эриткариоцитын ихэнх нь базофилийн
/улаан чөмөгний хөх шинж/
- 22.
- 23.
- 24.
- 25.
- 26.
- 28.
- 29.
Эмчилгээ
Энгийн дэглэм
Фуникулынмиелоз-стационарт эмчлэх
B12 баялаг хоол хүнс хэрэглэх- мах, өндөг, бяслаг сүү, элэг, бөөр
Цианкобаламин 200-500мкг 4-6 д/х турш
мэдрэлийн шинж- хоногт 2 удаа
мэдрэлийн шинж илрээгүй үед- 1 удаа
Гидроксикобаламин 500 мкг өнжөөд тарих 4д/х турш
5-7 дахь хоногт ретикулоцит ихсэж дээд
хэмжээндээ хүрэх /ретикулоцитийн криз/
- 30.
Барих эмчилгээ
Цко- 400-500мкг-аар 7 хон 1 удаа 2 сарын турш, дараа
нь сард 2 удаа 2-3 сар тарина
ГКо-эхний 3 сард 500 мкг долоо хоногт 1 удаа, дараа нь
байнга сард 1 удаа тарина
Ходоод тайрагдсан-Гб, эр хэвийн үед барих эмчилгээг
сард 1 удаа тарих
- 31.
Pernicious anemia Хоронцус багадалт
( Addison - Biermer )
Ходоодны париеталь эсүүдэд аутоиммуны урвал
явагдах
Париеталь эс болон дотоод хүчин зүйлийн эсрэг
эсрэг бие үүсэх
Мегалобласт анеми
Хэлний хөхлөг хатингарших
Мэдрэлийн шинж
- 32.
- 33.
- 34.
- 35.
- 36.
Pernicious anemia эмгэгжам
Насанд хүрэгч
Ходоод хатингарших:
•Ходоодны их бие хэсэг хамрагдах
•Ходоодны үндсэн эс болон parietal эсүүд мөхөх
•Нарийн гэдэсний метаплази
Өсвөр насны
•Аутосом реццесив
•Сонгомлоор ДХ дутагдах
- 37.
Pernicious anemia эмгэгжам
Төрөлхийн :
Эцэг эх Pernicious anemia өвдсөн байх
HLA-B7, DW2, DW5, DR2 хамааралтай
Autoimmunity:
Париеталь эсийн эсрэг эсрэг бие үүсэх: 85 %
ДХ эсрэг эсрэг бие үүсэх : 55 - 70 %
Бамбайн дааврын эсрэг эсрэг бие үүсэх
Бусад аутоиммуны өвчнүүд
- 38.
- 39.
- 40.
- 42.
Shilling Test
1. 1үе шат: радио идэвхит В12
уулгах
2. 24 цагийн турш шээсээр
ялгарах хэмжих
>5% хэвийн
<5% буурсан
3. 2 үе шат: дахин радио
идэвхит В12, ДХ өгөх
өөрчлөлтгүй=PA
өөрчлөгдөх= malabsorption
1 е шат р д нү ү ү 2 е шат р д нү ү ү Diagnosis
хэвийн -
Хэвийн эсвэл
В12 дутагдал
буурсан хэвийн
Pernicious
anemia
буурсан буурсан
Шимэгдэлт
алдагдах
- 43.
- 44.
- 45.
Фолийн хүчил
Хүнсний бүтээгдэхүүнболон бие махбодид
фолийн хүчлийн давс полиглутамат хэлбрээр
хадгалагддаг.
Хэвийн үед хүний биед хэрэгцээ 400mcg/day
жирэмсэн/ хөхүүл: 500-800mcg/day
Хүний биед 5-10mg нөөцлөгдөх
- 46.
- 47.
- 48.
- 1 аягажүржийн шүүс 82 mcg
- 1 порц ногоон бууцай 131 mcg
- 1 порц шар буурцаг 179 mcg
- 1 порц шош 141 mcg
- 1 зүсэм цагаан талх 20 mcg
Зарим хүнсэнд агуулагдах фолатын хэмжээ
- 49.
Фолийн хүчил
Хүнсний бүтээгдэхүүнболовсруулах явцад 50%-с
дээш
Сүүг буцалгаж ариутгахад 70-80% алддаг.
Хоол тэжээлээр орсон фолийн хүчлийн
80-90% моноглутамат
30% полиглутамат
- 50.
Шалтгаан
1. Хоол хнсээрээ фолийн х члийг хангалтг й авсанү ү ү
2. Архаг архидалт, архины хордлого
3. Х хдийг х хний с гээр хооллохг й байхүү ө үү ү
4. Дутуу т р хө ө
5. Ихэр х хд дүү үү
6. Фолийн х члийн шимэгдэлт алдагдахү
7. Жирэмслэлтээс хамгаалах эм дүү
8. Эмийн н лө өө
ФХ шимэгдэлт бууруулах эм /циклосерин, уналт таталтийн эсрэг эм дифенин
фенобарбитал, сахар бууруулдаг эм метформин бигуанид/
Дигидрофолат редуктаза дарангуйлагч эм /халдварын эсрэг эм хлоридин
бисептол, цитостатик эм метотрексат/
9. Цус задрал
10.Цусны болон бусад хавдарууд
11. Фолийн х члийн зарцуулалт ихсэхү
- 51.
Цус багадалтийн ерөнхийшинжүүд
Ихэвчлэн хүүхэд залуу эмэгтэйчүүд өвчилнө
-Нүдний склер шарангадуу
- Эпилепситэй хүмүүст уналт нь ойртох
-Шизофренитэй хүмүүст сэдрэл нь ихсэдэг
Шинж тэмдэг
- 52.
1. ЦДШ- ВитВ12 дутлын цус багадалттай
адил
2. Биохимид- Сийвэн дэх Фх-н хэмжээ
буурсан байна
3. Миелограммд- мегалобласт хэлбэрийн
цус төлжилт буюу хөх чөмөгний шинж
илэрнэ.
Оношлогоо
- 53.
15гр гистидинийг өвчтөндуулгаад шээсээр гарах
формимин глутамины хүчлийг хэмждэг.
Хэвийн үед- шээсээр 1-18мг формимин глутамины
хүчил ялгардаг
/ гистидин глутамины хүчлийн нийлэгжилтэнд
оролцдог/
Фолийн хүчил дутагдалын үед-гистидин хэрэглэсний
дараа шээсээр ялгарах формимин глутамин 20-1500
дахин ихэсдэг.
Фолийн хүчлийн дутагдал илрүүлэхэд
Гистидиний ачаалалтай сорил
- 54.
- 55.
Мегалобласт цус багадалтынялган оношилгоо
Эмнэлз йн шинжү В12 дутагдал Фолатын дутагдал
Асуумж:
Хоол х нсү
Архидалт
Хорон цус багадалт
Байнга биш
Тохиолдохг йү
Ихэнхдээ тохиолдох
Байнга тохиолдох
Архаг архидалт
байхг йү
злэгҮ :
Мэдрэлийн рчл лтөө ө илрэх илрэхг йү
Шинжилгээ:
Сийвэнгийн В12 багасах
Сийвэнгийн фолатын
т вшин буурах 3-20ү
нг/мл
ДХ эсрэг эсрэг бие сэхүү
Шээсээр ФГХ гарах
Шээсээр ММХ гарах
Ходоод шинжлэх
Багасах
60-40 нг/мл
70-с дээш %илрэх
Байх
Байх
Ахили тод илрэх
ДХ дутагдал
Хэвийн
Багасах
Илрэхг йү
Байх
Байхг йү
Ходоодны х чил, пепсин,ү
ДХ хэвийн
Эмчилгээ:
В12 тарих
Фолийн х чил хэрэглэхү
Ретикулоцит с хө ө
Хариу урвал г хг йө ө ү
Хариу урвал г хг йө ө ү
Ретикулоцит с хө ө
- 56.
Editor's Notes
- #3 (
- #8 дутаг
- #29 Study of 729 random from the community, no asian or hispanic folks were+